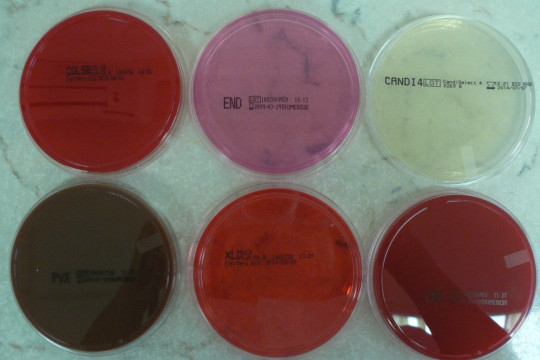
9. Agarové kultivační půdy
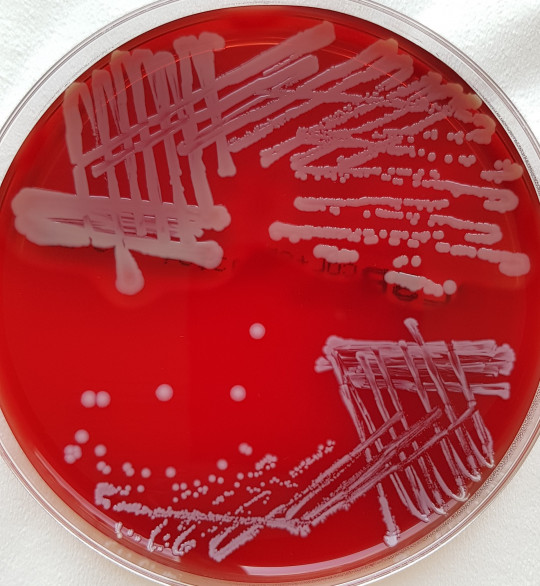
10. Křížový roztěr
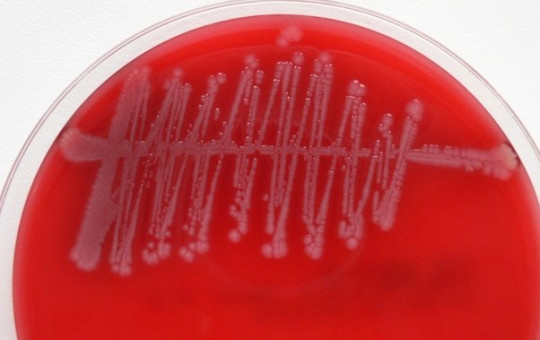
11. Semikvantitativní kultivace moče

5.2
Přímý průkaz kultivačně
Kultivační vyšetření má v mikrobiologii zásadní význam. Pozitivní kultivace jednoznačně potvrdí přítomnost mikroba ve vzorku, umožní jeho identifikaci a umožní stanovení citlivosti k antimikrobním látkám.
Na kultivačních půdách lze kultivovat bakterie, kvasinky a plísně. Viry lze kultivovat pouze na tkáňových kulturách.
5.2.1
Kultivace bakterií a mykotických mikroorganismů
5.2.1.1
Kultivační půdy
Kultivační média (kultivační půdy) se rozdělují na:
- tekuté, tzv. bujóny – slouží především k pomnožení mikrobů.
Příkladem pomnožovací tekuté půdy je mozkosrdcový bujón (brain heart infusion BHI) nebo pomnožovací půda pro střevní patogeny (selenitový bujón).
- pevné, tzv. agary.
Pevné kultivační půdy vznikají přidáním agaru (z mořské řasy) do tekuté půdy. Připravují se do Petriho misek nebo v určitých případech do zkumavek.
Podle účelu použití a obsahu jednotlivých složek se dělí na:
- Základní půdy – bohaté na živiny a růstové faktory (př. játrový bujón).
- Obohacené půdy – vzniknou přidáním speciálních růstových složek.
- Selektivní půdy – vzniknou přidáním látek, které růst určitých druhů omezují, nebo v nich naopak některá složka chybí. To umožní růst pouze vybraných druhů, které chceme tímto postupem izolovat.
- Diagnostická půda – obsahuje specifické složky, které určité druhy metabolizují. Díky barevnému indikátoru umožní vizuální zařazení do skupiny, nebo přímo identifikaci mikroba (př. půdy obsahující různé druhy cukrů).
- Selektivně-diagnostické půdy – kombinují vlastnosti obou předchozích. V diagnostice se využívají rutinně. Patří mezi ně např. Endův agar. MacConkey agar…
- Transportní půdy – jsou určené pro odběrové soupravy a transport vzorku do laboratoře. Umožňují přežití mikrobů, ale zároveň nepodporují jejich růst (př. Amiesovo médium).
- Půdy pro mykologickou kultivaci – Sabouraudův agar, pro vláknité houby Czapek-Dox agar.
+
Obr. 9. Agarové kultivační půdy
5.2.1.2
Očkování kultivačních půd
Při kultivačním zpracování se vzorek tzv. očkuje na kultivační půdy. Podle druhu vzorku a cíle vyšetření je zvolena sada kultivačních médií. Vzorek je asepticky nanesen na kultivační půdu – do tekuté pipetou nebo bakteriologickou kličkou, na pevnou tamponem nebo bakteriologickou kličkou. Poté je vzorek rozočkován tzv. křížovým roztěrem. K rozočkování se používá jednorázová bakteriologická klička nebo klička z drátu, která se opakovaně sterilizuje v plameni. Cílem křížového roztěru je získání izolovaných kolonií na konci roztěru tak, aby je bylo možné pozorovat a izolovat, tzn. odebrat kličkou a přenést na jinou kultivační půdu. Tím se zajistí získání tzv. čisté kultury.
+
Obr. 10. Křížový roztěr
Ke kultivaci některých vzorků (hemokultury, vzorky pro diagnostiku mykobakterií) se používají uzavřené systémy, někdy nazývané metabolická kultivace. Materiál je přímo odebrán do odběrové soupravy (lahvičky) s kultivačním médiem. V laboratoři je lahvička vložena do přístroje, ve kterém probíhá automaticky sledování metabolické aktivity. Zaznamená-li přístroj aktivitu růstu, ohlásí pozitivitu a se vzorkem se dále pracuje manuálně. Tyto systémy mají vysokou senzitivitu a znamenají také úsporu práce v laboratoři.
5.2.1.3
Zvláštní zpracování vybraných druhů klinického materiálu
Zpracování močí
Vzorek moče se nejčastěji zpracovává semikvantitativně, kromě přítomnosti bakterií se hodnotí také jejich počet v 1 ml moče. Za signifikantní bakteriurii je považováno množství 105 CFU (colony forming unit) v 1 ml moče. Rutinně se využívá vyočkování vzorku kalibrovanou kličkou o objemu 1 µl na krevní agar, půdy pro gramnegativní tyčinky, event. chromogenní agar. V některých případech lze využít paralelní vyočkování kličkou o objemu 10 µl. V případě použití 1µl kličky se výsledná kvantita hodnotí podle počtu CFU na kultivační půdě takto:
- 1–10 CFU – 103 v 1 ml
- 10–100 CFU – 104 v 1 m
- 100–1000 CFU – 105 v 1 ml
- 1000–10 000 CFU – 106 v 1 ml
- 10 000–100 000 CFU – 107 v 1 ml
- 100 000–1 000 000 CFU – 108 v 1 ml
Výsledná interpretace zohledňuje jednak kvantitu, ale zároveň stav nemocného, druh bakterie, typ vzorku (moč ze středního proudu, moč cévkovaná, …) a typ infekce.
+
Obr. 11. Semikvantitativní kultivace moče
Zpracování katétrů
Tímto způsobem se zpracovávají intravaskulární katétry. Hodnocení je semikvantitativní, nejpoužívanější metoda je dle Makiho. Čtyřcentimetrový konec katétru se poválí po celém povrchu agarové plotny (krevního agaru). Po inkubaci se počítají CFU, jako známka infekce se hodnotí minimální počet 15 CFU.
5.2.2
Kultivace virů
U virů hovoříme spíše než o kultivaci o izolaci viru. Základní podmínkou je živá hostitelská buňka. K těmto účelům se využívají buď tzv. tkáňové kultury, kuřecí embrya nebo pokusná zvířata (bílá myš, sající myšata, morče …). V rutinní praxi se využívají především tkáňové kultury.
Izolace virů je vysoce specializovaná metoda, choulostivá na podmínky, sterilitu. Vyžaduje speciální vybavení laboratoře, speciální mytí používaného skla, netoxické plasty, vysoce purifikovanou vodu a přesné složení kultivačních médií. Pro růst buněk se využívají tzv. Roux lahve (čti Rú), živná média obsahují glukózu, aminokyseliny, vitamíny, růstové faktory, fenolovou červeň, antibiotika a bovinní sérum.
Po nárůstu souvislé vrstvy buněk na stěnách Roux lahve se médium slije, přidáním trypsinu se buňky uvolní od stěny lahve, vzniklá suspenze buněk se stáhne pipetou a po kontrole životaschopnosti buněk se mohou pasážovat s novým živným médiem do nové lahve. Pokud se vymění živné médium za udržovací (chudší, bez séra), je buněčná kultura připravená k naočkování viru.
Růst viru se tkáňové kultuře projeví destrukcí nebo změnou tvaru buněk, tzv. CPE (cytopatický efekt). V tekutině kultury zůstanou viry a jejich antigeny, používá se k dalším testům a k identifikaci.
5.2.2.1
Buněčné kultury
Jako buněčné kultury se ve virologii využívají buňky zvířecí i lidské. Podle stáří a množství tzv. pasáží je můžeme rozdělit do tří skupin.
- Primární linie – jsou tvořeny buňkami odebranými přímo z organismu, mají krátkou životnost.
- Buněčné kmeny – vznikají z primárních kultur z buněk již minimálně jednou pasážovaných. Jsou to normální diploidní buňky, vydrží přibližně 40–50 dělení, pak zaniknou. Příkladem jsou lidské embryonální plíce LEP (získané z lidských plodů zdravých žen při interrupci).
- Buněčné linie – jsou to heteroploidní kultury buněk s téměř neomezenou životností a schopností se neomezeně dělit při zachování všech svých vlastností. Vznikají z buněčných kmenů transformací (typ přenosu genetické informace) nebo jde o nádorové buňky, u kterých je vyřazena přirozená regulace růstového cyklu. Příkladem buněčných linií jsou HeLa buňky izolované již v padesátých letech 20. století od pacientky z karcinomu děložního hrdla, lidské buňky Hep-2 (lidské epiteliální buňky z karcinomu hrtanu), opičí Vero buňky a MK2 (z ledvin) nebo buňky psích ledvin MDCK.